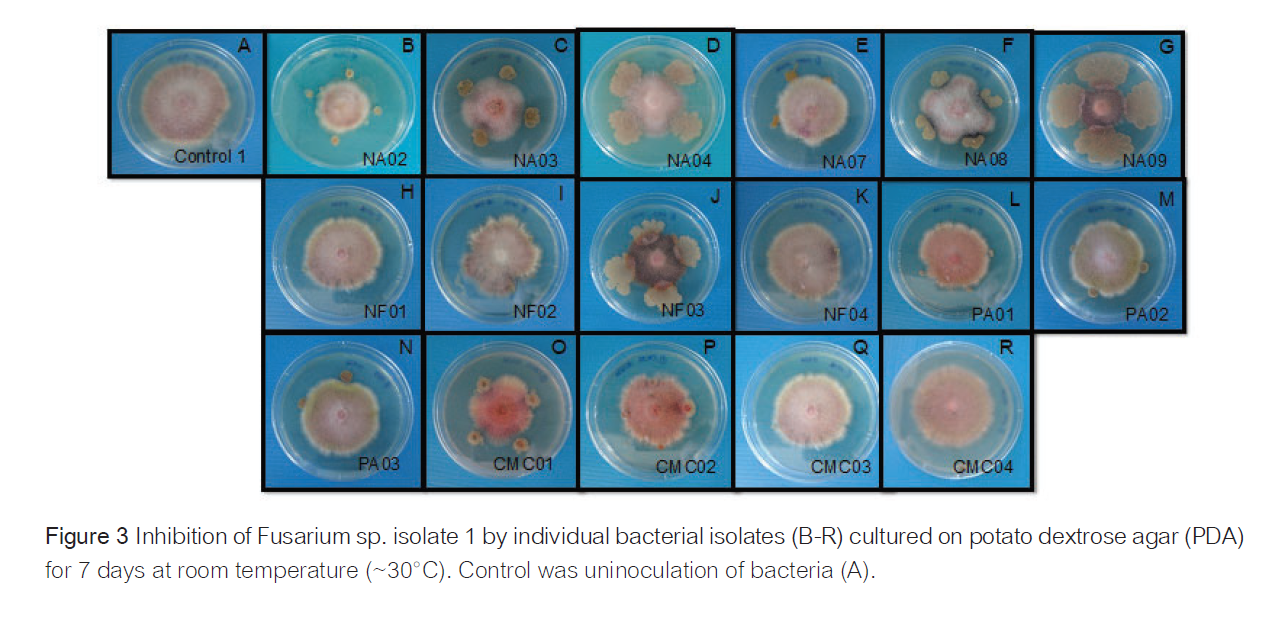
ยับยั้งเชื้อรา: ทดสอบจริงในจานเพาะเชื้อ พบการยับยั้ง Fusarium ได้อย่างชัดเจนถึง 40 - 53%

บทความ
เพชพระกาฬ : หยุดโรคเน่า คุมใบอ่อน สั่งทุเรียนให้ติดผลดก ด้วยกลไกธรรมชาติ 100%
เพชพระกาฬ: หยุดโรคเน่า คุมใบอ่อน สั่งทุเรียนให้ติดผลดก ด้วยกลไกธรรมชาติ 100% ผลงานวิจัยร่วมกับมหาวิทยาลัยเกษตรศาสตร์ และ สวทช. (ITAP) ยืนยันประสิทธิภาพจริงในแปลงทุเรียน
“โรครากเน่าโคนเน่า และ ใบอ่อนแตกช่วงหางแย้… ฝันร้ายของคนทำทุเรียน” คุณกำลังเจอปัญหาเหล่านี้ใช่ไหม?
- เชื้อรา Fusarium ลงราก ต้นโทรม ยืนต้นตาย รักษาไม่หาย
- ฝนหลงฤดู ไนโตรเจนพุ่ง ทุเรียนแตกใบอ่อน แย่งอาหารลูก
- หางแย้ร่วง ผลอ่อนหลุดร่วง เพราะคุมไนโตรเจนไม่อยู่
“เพชรพระกาฬ” คือคำตอบที่ผ่านการพิสูจน์แล้ว ด้วยงานวิจัยทางวิทยาศาสตร์ที่แก้ปัญหาที่ต้นเหตุ: “ดิน”
กลไกที่ 1: เกราะป้องกันโรค (Disease Defense)
“ปรับสภาพดิน ไล่เชื้อร้าย เติมเชื้อดี”
โรครากเน่าโคนเน่าส่วนใหญ่เกิดจากเชื้อรา Fusarium spp. ที่ชอบดินเป็นกรด เราจัดการด้วยระบบ Double Action :
- ปรับบ้านของดินให้เชื้อร้ายอยู่ยาก: ปรับค่า pH ดินให้สูงถึง 8.69 (ด่าง) ด้วยแคลเซียมไฮดรอกไซด์ ซึ่งเป็นสภาวะที่เชื้อรา Fusarium ไม่ชอบและหยุดการเจริญเติบโต
- ส่งเชื้อดีกำจัดเชื้อร้าย : เติมจุลินทรีย์สายพันธุ์แกร่ง (Isolate NA08, NA09) ที่ผ่านการคัดแยกแล้วว่าสามารถ “ยับยั้งเชื้อรา Fusarium ได้สูงสุดถึง 50-53%” เชื้อดีจะเพิ่มจำนวนขึ้น 10 เท่าภายใน 18 วัน เพื่อเข้ายึดพื้นที่แทนเชื้อโรค
- ข้อแนะนำการใช้
- ใส่ระยะฟื้นต้นทุเรียนหรือเพื่อป้องกันโรค
- ใส่ระยะใบเพสลาด
- อัตราการใช้แนะนำ
– รัศมีทรงพุ่ม ไม่เกิน 2 เมตร 3 กก./ต้น และเพิ่มอัตรา 1 กก./1 เมตร
- เพิ่มอัตราการใช้ขึ้นกับสภาพอากาศและความรุนแรงของปัญหา
- แนะนำใช้เพื่อป้องกันโรค และใช้ร่วมกับสารชีวภัณฑ์หรือสารเคมีกำจัดโรคพืช

กลไกที่ 2: เทคนิคแกล้งดิน (Nitrogen Management)
“สั่งหยุดใบอ่อน เซฟหางแย้ ผลอ่อน ด้วยเทคนิค Nitrogen Drawdown”
ช่วงลูกเท่าไข่ไก่หรือหางแย้ สิ่งที่น่ากลัวที่สุดคือ “ไนโตรเจนเกิน” จนแตกใบอ่อน เราใช้เทคนิคทางชีวภาพจัดการ :
- ดูดซับชั่วคราว: เมื่อใส่ผลิตภัณฑ์ลงดิน จุลินทรีย์เข้มข้นจะดึง “ไนเตรทและแอมโมเนียม” ในดินไปใช้ในการย่อยสลายอินทรียวัตถุ
- ผลลัพธ์: ไนโตรเจนในดินจะลดต่ำลงอย่างมีนัยสำคัญในช่วง 18 วันแรก
- ประโยชน์: เมื่อไนโตรเจนลดลงชั่วคราว “ต้นทุเรียนจะหยุดสร้างใบอ่อน” แต่จะส่งอาหารไปเลี้ยงผลแทน ลดการหลุดร่วงของผลอ่อนได้อย่างชะงัด
- คืนปุ๋ยให้ตอนจบ: หลังพ้นวิกฤต (30 วัน) จุลินทรีย์จะค่อยๆ ปลดปล่อยไนโตรเจนกลับคืนสู่ดิน ให้ลูกทุเรียนนำไปใช้ขยายขนาดผลต่อได้ทันที
✅ ข้อแนะนำการใช้ป้องกันผลร่วง
- ใส่ระยะดอกบาน-ผลอ่อน หรือช่วงที่ต้องการหยุดไนโตรเจนทางดิน
- ใส่ระยะใบเพิ่งเริ่มแทง
- อัตราการใช้แนะนำ
– รัศมีทรงพุ่ม ไม่เกิน 2 เมตร 3 กก./ต้น และเพิ่มอัตรา 1 กก./1 เมตรรัศมีทรงพุ่ม
- แนะนำใส่เพื่อป้องกันพร้อมฉีดพ่นธาตุอาหารทางใบ
- เพิ่มอัตราการใช้ขึ้นกับสภาพอากาศและความรุนแรงของปัญหา

บทพิสูจน์จากห้องแล็บสู่แปลงจริง อ้างอิง: วารสารวิทยาศาสตร์เกษตรและการจัดการ (2025)
✅ เพิ่มจุลินทรีย์ดี 10 เท่า: จาก 10,000 เป็น 100,000 CFU/g ภายใน 18 วัน

✅ ยับยั้งเชื้อรา: ทดสอบจริงในจานเพาะเชื้อ พบการยับยั้ง Fusarium ได้อย่างชัดเจนถึง 40 – 53%
✅ ลดไนโตรเจนส่วนเกิน: ปริมาณแอมโมเนียมและไนเตรตลดลงจริงในช่วง 18 วันแรก ช่วยชะลอการแตกใบอ่อน

💡 เทคนิคการใช้ให้ได้ผลสูงสุด:
“เพื่อป้องกันหางแย้ ผลอ่อน ร่วงจากการแตกใบอ่อน แนะนำให้ใส่ เพชรพระกาฬ เพื่อป้องกัน ในช่วงระยะดอกบาน กรณีพบปัญหาฝนตก ใบอ่อนแตก แนะนำเพิ่มอัตราการใช้จากที่แนะนำ 1 เท่า เพื่อให้จุลินทรีย์เริ่มทำงานดึงไนโตรเจนลงได้ทันเวลา พอดีกับจังหวะที่พืชกำลังจะแตกใบอ่อน ทุเรียนของท่านจะนิ่ง ใบไม่ไหล ลูกไม่ร่วงครับ”
เปลี่ยนดินเสีย ให้เป็นดินสั่งได้ ปกป้องทุเรียนของคุณด้วยเทคโนโลยีชีวภาพระดับงานวิจัย
อ้างอิง : วารสารวิทยาศาสตร์เกษตรและการจัดการ Journal of Agricultural Science and Management. Online ISSN: 2985-1904 คณะเกษตร กำแพงแสน มหาวิทยาลัยเกษตรศาสตร์ วิทยาเขตกำแพงแสน ปีที่ 8 ฉบับที่ 2 (2025): พฤษภาคม-สิงหาคม 2568
ลิงค์ : https://li02.tci-thaijo.org/index.php/JASM/article/view/755
👉 สั่งซื้อสินค้า / ปรึกษาผู้เชี่ยวชาญคลิก
Line : https://line.me/R/ti/p/%40857ntkdl


